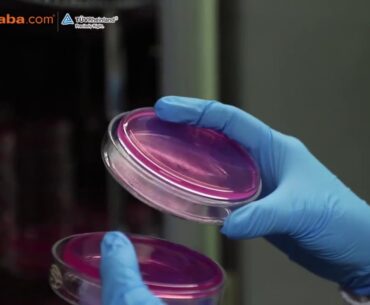
Guangdong Yichao Biological - A Leading Gummy Vitamin Manufacturer on Alibaba

VETENEX Flipkart Shop :- We are The Topmost Manufacturer, Exporter, Supplier & Marketing of a wide range of Supreme Quality Animal Feed Supplement & Veterinary Products For Better Health , Growth, Reproduction & Production of Livestock Animals. We have a…